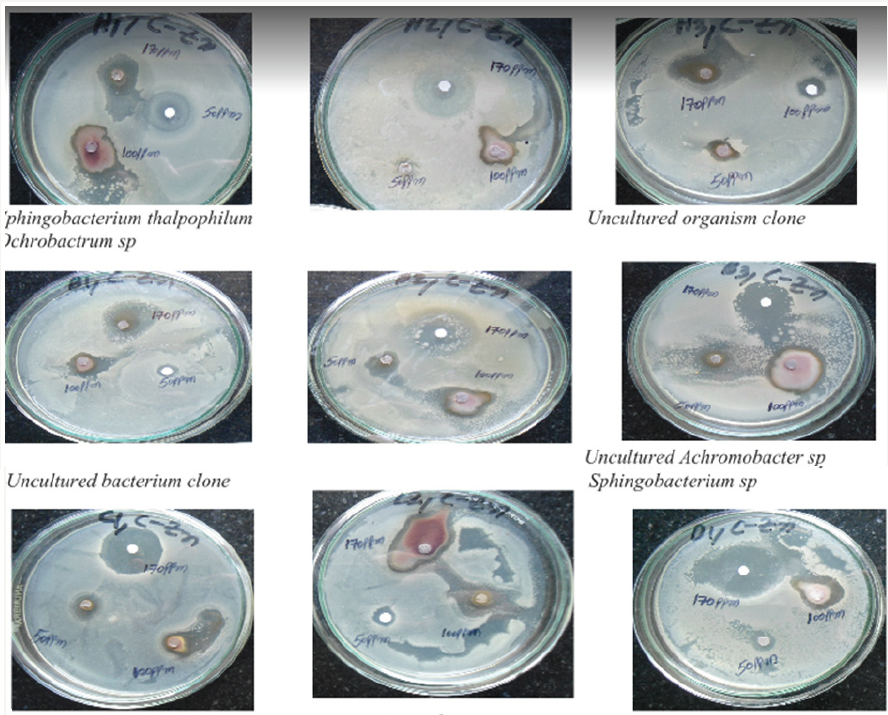
Click here to view Large Plate 2

Supraja N and Prasad TNVKV*
Nanotechnology laboratory, Acharya NG Ranga Agricultural University, India
*Corresponding author: ANanotechnology laboratory, Institute of Frontier Technology, Regional Agricultural Research Station, Acharya N G Ranga Agricultural University, Tirupati-517502, AP, India
Submission: August 24, 2017; Published: September 08, 2017
ISSN : 2576-8816Volume1 Issue3
Cinnamomum zeylanicum have lot-of biological activities including antimicrobial, antioxidant and antifungal properties. Furthermore, cytotoxic and apoptotic activities of several constituents were identified throughout its biological properties. Bark of Cinnamomum zeylanicum (Lauraceae) collected respectively at Nanotechnology laboratory (ANGRAU, Tirupathi, India). In this study, microbiological aspects of scale formation in PVC pipelines bacteria and fungi were isolated. Stable Zn nanoparticles were formed by treating 90ml of 1mm zinc nitrate aqueous solution with 10ml of 10% bark extract. The formation of Cinnamomum zeylanicum bark extract mediated zinc nanoparticles (CZnNPs) was confirmed by UV-visible spectroscopic analysis and recorded the localized surface plasmon resonance (LSPR) at 270nm. Fourier transform infrared spectroscopic (FT-IR) analysis revealed that primary and secondary amine groups in combination with the proteins present in the bark extract are responsible for the reduction and stabilization of the CZnNPs. The morphology and crystalline phase of the nano crystals were determined by Transmission electron microscopy (TEM) and (XRD). The hydrodynamic diameter (20.3mm) and a positive zeta potential (10.4mV) were measured using the dynamic light scattering technique. The antimicrobial activity of CZnNPs was evaluated (in vitro) against fungi, Gram-negative and Gram-positive bacteria using disc diffusion method which were isolated from the scales formed in drinking water PVC pipelines.
Keywords:Zinc nanoparticles; Fungal sp; Gram negative; Gram positive bacteria; bark extract of cinnamomum zeylanicum
Metal nanoparticles are intensely studied due to their unique optical, electrical and catalytic properties. To utilize and optimize chemical or physical properties of nano-sized metal particles, a large spectrum of research has been focused to control the size and shape, which is crucial in tuning their physical, chemical and optical properties [1]. Various techniques, including chemical and physical means have been developed to prepare metal nanoparticles, such as chemical reduction [2], electrochemical reduction [3], photochemical reduction [4], heat evaporation [5] and so on. In most cases, the surface passivator reagents are needed to prevent nanoparticles from aggregation. Biosynthesis of nanoparticles has received considerable attention due to the growing need to develop environmentally benign technologies in material synthesis. For instance, a great deal of effort has been put into the biosynthesis of inorganic materials, especially metal nanoparticles using microorganisms [6,7]. Both live and dead microorganisms
are gaining importance by virtue of their facile assembly of nanoparticles. Moreover, the problems concerning the synthesis of nanoparticles and their stabilization can be solved in tandem and mild conditions. Use of plant extract for the synthesis of nanoparticles could be advantageous over other environmentally benign biological processes by eliminating the elaborate process of maintaining cell cultures. Green synthesis of metal nanoparticles from plants is an interesting aspect as the process is eco-friendly, and non-toxic. Metal nanoparticles are successfully synthesized by green synthesis route. Various workers synthesized silver [8], gold [9,10], titanium dioxide [11], tungsten oxide [12], and copper oxide [13]. But the synthesis of biogenic zinc nanoparticles is scant [14,15]. Zn nanoparticles appear to be strongly resisted to bacteria and fungi. The purpose of this study was to design and synthesis Zn nanoparticles and investigates the antibacterial and antifungal activities. Cinnamomum zeylanicum tree belongs to the family, Lauraceae most noted for its bark, which provides the world with the commonly known culinary spice, cinnamon. Cinnamon has medicinal property and has been used to treat gastrointestinal complaints and other ailments [16]. Cinnamon possesses antiallergenic, anti-inflammatory, anti-ulcerogenic, antipyretic, antioxidant, anaesthetic activities [17]. This study aimed to analyze the chemical composition of the bark extract obtained from C. zeylanicum its inhibitory effect on the bacteria and fungi. To the best of our knowledge, however, there is no report on antimicrobial activity of aqueous extract of this plant through Zn nanoparticles synthesis. The present work therefore, attempts to evaluate the antimicrobial activity (Biofilm degradation in drinking water pipelines) of the aqueous extract towards pathogenic fungi and bacteria by in vitro disc diffusion method.
Zinc nitrate (& gt; 99% pure) was purchased from Sigma Aldrich, India. Potato dextrose broth, Potato dextrose agar, Nutrient broth, Nutrient agar plate, was supplied by Hi-media, India. Collection of biofilm formed in poly vinyl chloride (PVC) pipes The PVC Biofilm samples were collected from four different regions located in and around Tirupati, (Chittoor District) Andhra Pradesh, India. The samples were collected from drinking water PVC pipelines and taken in the sterile container. These samples were stored in an ice box and transported to the laboratory for microbiological characterization [18].
Collection of plant materialHealthy Cinnamomum zeylanicum stem barks were collected from Tirumala hills, Andhra Pradesh state, India. From the selected plant bark was collected by scrapping the trunk using neat and clean knife during the month of July 2014 and collected material was carefully washed and dried at 45 °C to constant weight. The dried bark of plant material were powdered, passed through a BSS no. 85-mesh sieve and stored in air tight container.
Isolation of fungal and bacterial sp. from drinking water pipelineEight fungal species and ten bacterial samples were isolated from drinking water supply PVC pipelines in Tirupati, Chittoor district, AP, India. Through serial dilution pour plate technique, fungal sp. was isolated using potato dextrose agar (PDA) medium and Gram-negative and Gram-positive bacteria were isolated from nutrient agar medium. Further, it is maintained in potato dextrose agar slants (fungi) and nutrient agar slants (bacteria) for onward analysis [19].
Preparation of cinnamomum zeylanicum zinc nanoparticles90ml aqueous solution of 1.0×10 -3M Zinc nitrate was mixed with a 10ml of 10% aqueous solution of Cinnamomum zeylanicum stem bark extract. The samples were then centrifuged using REMI K 70 at 12,000rpm for 15min to get clear supernatant. The initial concentration of the CZnNPs was measured using inductively coupled plasma optical emission spectrophotometer (ICP-OES) and was found to be 296±0.8ppm. Then, diluted the sample to different concentrations of 170, 100, 50ppm and were used to investigate the concentration dependent antimicrobial effect of CZnNPs. Measurement of concentration of CZnNPs using inductively coupled plasma optical emission spectrophotometer (ICP-OES) The concentrations of the CZnNPs were measured using ICP-OES (Prodigy XP, Leeman Labs, USA). The samples were prepared with 10 times dilution after centrifugation at 4,000rpm for 15min. Then, 20ml of aliquot was loaded to the racks of automatic sampler and estimated the concentration of CZnNPs thrice [20].
Assay for antimicrobial activity of CZnNPsThe antimicrobial activity of CZnNPs was determined on the basis of colony formation (CFU) by in vitro Petri dish assays (disc diffusion). Each fungal and bacterial isolates was cultured on growth media that induced prolific conidia and bacterial production. The fungi isolates were grown on potato dextrose agar medium, and bacterial isolates were grown on nutrient agar medium. Conidia were collected from cultures that were incubated at 37 °C for 10 days (fungi), and bacterial cultures were collected from cultures that were incubated at 37 °C for 2 days for (bacteria) and diluted with sterile, deionized water to concentration of 106 sporesml 1. Aliquots of the conidial suspension and bacterial suspension were mixed with serial concentrations of silver preparations to a final volume of 1ml and were also mixed with sterile, deionized water as control. A 10μl subsample of the conidia and Cinnamomum zeylanicum Zn mixture stock was taken at 50±0.9, 100±1.1 and 170±1.4ppm after Zn treatments and diluted 100-fold with the deionized water. A 10μl aliquot of the diluted spore suspension was spread on PDA (Becton, Dickson and Company, Sparks, MD) medium. Three PDA plates for fungi and three NA plates for bacteria per each combination of exposure Cinnamomum zeylanicum Zn concentration were tested. The filter paper disc dipped in different ppm and inserted on mediums (PDA), and then, the plates were incubated at 37 °C for 2-4 days for fungi and bacteria, respectively. The average number of colonies from silver-treated spore suspensions (fungi) and (bacteria) was compared with the number on the water control (percent colony formation). The zone size was determined by measuring the diameter of the zone in mm.
UV - Visible spectrum for synthesized nanoparticles the nanoparticles were monitored by UV-visible spectrum at various time intervals. The UV-Visible spectra of this solution was recorded in spectra 50 Analytikjena Spectrophotometer, from 250 to 400nm.
The nanoparticles were harvested and characterized by FTIR. The FTIR spectrum was taken in the mid IR region of 400-4000 cm1. The spectrum was recorded using ATR (attenuated total reflectance) technique. The sample was directly placed in the KBr crystal and the spectrum was recorded in the transmittance mode.
The aqueous suspension of the synthesized nanoparticles was filtered through a 0.22μm syringe driven filter unit and the size of the distributed nanoparticles were measured by using the principle of Dynamic Light Scattering (DLS) technique made in a Nanopartica (HORIBA, SZ-100) compact scattering spectrometer.
The nanoparticles were harvested and characterized by XRD and TEM. The XRD pattern was recorded using computer controlled XRD-system, JEOL, and Model: JPX-8030 with CuK radiation (Nifiltered= 13418 Ao) at the range of 40kV, 20A. The ‘peak search’ and ‘search match’ program built in software (syn master 7935) was used to identify the peak table and ultimately for the identification of XRD peak.
The nanoparticles were harvested and characterized by XRD and TEM. The XRD pattern was recorded using computer controlled XRD-system, JEOL, and Model: JPX-8030 with CuK radiation (Nifiltered= 13418 Ao) at the range of 40kV, 20A. The ‘peak search’ and ‘search match’ program built in software (syn master 7935) was used to identify the peak table and ultimately for the identification of XRD peak.
The morphology of the nanoparticles was characterization by Transmission electron microscopy was performed on JEOL (JEM-1010) instrument, with an accelerating voltage of 80kvafter drying of a drop of aqueous Zn nanoparticles on the carbon-coated copper TEM grids Samples were dried and kept under vacuum in desiccators before loading them onto a specimen holder. The particle size distribution of nanoparticles was evaluated using ImageJ 1.45s software [21].
All of the data from three independent replicate trials were subjected to analysis using Statistical package for the Social Sciences (SPSS) version 16.0. The data are reported as the mean+SD and significant differences between mean values were determined with one way analysis of variance (CRD) followed by Duncan’s multiple range test (DMRT) (P<0.05).
Figure 1: Show that cinnamomum zeylanicum bark poweder.

Figure 2: Zinc nanoplate poweder colour changes from white to cream colour (synthesis of Zn nanoplate by cinnamomum zeylanicum bark extract).

Selection of fungi and bacteria present in drinking water pipeline and synthesis of Zn nanoparticles Drinking water pipeline bacteria and fungi species have unusual biological activities depending upon the metabolisms under temperature, pH and pressure. Once the bark (Figure 1) extract (10ml) was treated with 90 ml of Zn nitrate solution, the color of zinc nitrate solution is color less when mixing with Cinnamomum zeylanicum shown pale yellow color (Figure 2). Zn nanoparticles were characterized by using the techniques like, Fourier transform infrared spectro photometry, (FTIR), UVVis spectrophotometry, Dynamic light scattering (Particle size), zeta potential, X-ray diffraction (XRD) and transmission electron microscopy (TEM).
The absorption spectrum was recorded for the sample in the range of 200-800mm (Figure 3). The spectrum showed the formation of peak in the wavelength of 270nm. UV-Vis Spectroscopy was used to determine the formation and the stability of the synthesized zinc nanoparticles in aqueous colloidal solution. The bio matrix present in the stem bark extract of Cinnamomum zeylanicum may leads to the change in the absorbance and transmittance of UV- Vis spectra. The bio-reduction of zinc nanoparticles is extracellular and promises the vast development of green synthesis of metallic nanoparticles using the plants and plant bark sources.
Figure 3: Showing UV-visible spectroscopy recorded using cinnamomum zeylanicum bark extract of Zn nanoplate.

The functional groups - alcohols, phenols, alkenes, alkanes, carbonyls, aromatics, nitro compounds, alkyl halides and aliphatic amines were identified from FTIR spectrum recorded from the bark extract of Cinnamomum zeylanicum (Figure 4). The spectrum showed the bands for the functional groups located at 3354.98, 2884.38, 2084.45, 1631.31, 1406.99 and 589.99cm -1. The peak present at 3354.98 indicates C-H stretching vibration of alkynes. The peak present at 2884.38 indicates C-H stretching vibration of alkanes. The peak present at 2084.45 indicates -C≡ C- stretching vibrations of alkynes. The strong band of -C=O- stretch (carboxylic acids) was recorded at 1631.31cm -1. The peak present at 1406.99cm -1 indicates c-c stretching vibration of aromatics. The peak present at 589.99cm -1 indicates C-Br stretching vibration of alkyl halides. From the FTIR spectra of Cinnamomum zeylanicum bark extract and sample, change in wave number of the functional groups was observed due to the reduction and stabilization of metal group Zn [22]. When the spectrum of Cinnamomum zeylanicum bark extract was compared with the spectrum of sample, the functional groups of alkynes, alkanes and carboxylic acids were observed from the spectrum of sample due to the stretching of alkynes and alkanes (H-C=O), and carboxylic acids (-C=O- ) bands.
Figure 4: FTIR spectroscopy recorded using cinnamomum zeylanicum bark extract of Zn nanoplate.

XRD patterns of Cinnamomum zeylanicum bark extract mediated synthesis of Zn Nanoparticles shows the peaks were assigned to diffraction signals of (100), (002), (101), (102), (110), (103), (200), (112), (201), (004) and (201). The intensity data were collected over a 2θ range of 20-80 o. A definite line broadening of the XRD peaks indicates that the prepared material consists of particles in nanoscale range (Figure 5). From this XRD patterns analysis, we determined peaks intensity, position and width, full width at halfmaximum (FWHM) data. The diffraction peaks located at 31.84°, 34.52°, 36.33°, 47.63°, 56.71°, 62.96°, 68.13 °C, 69.18 °C, 70.16 °C, 73.21°C and 78.56 °C have been indexed as hexagonal wurtzite phase of Zn [23]and further it also confirms the synthesized nanopowder was free of impurities as it does not contain any characteristics XRD peaks other than Zn. The synthesized Zn nanoparticles diameter was calculated using Debye-Scherrer’s formula [24].
Figure 5: XRD pattern of Zn nanoplates synthesized using cinnamomum zeylanicum bark extract.

d= 0.89λ
βcosθ
Where 0.89 is Scherrer’s constant, λ is the wavelength of X-rays, ϴ is the Brag diffraction angle, and β is the full width at half-maximum (FWHM) of the diffraction peak corresponding to plane (101). The average particle size of the sample was found to be 16.21mm which is derived from the FWHM of more intense peak corresponding to 101 plane located at 36.33 °C using Scherrer’s formula.
Particle size and zeta potential values were measured using Nanopartica SZ-100. The particle size distribution spectra for the zinc nanoparticles were recorded as diameter (nm) verses frequency (%/nm) spectra with diameter (nm) on x-axis and frequency (%/nm) on y-axis. The zeta potential spectra for the zinc nanoparticles were recorded zeta potential verses intensity spectra with zeta potential (mV) on x-axis and intensity (a.u) on y-axis. Particle size of 20.3nm with zeta potential of -30.5mV was recorded for the zinc nanoparticles synthesized from Cinnamomum zeylanicum bark extract (Figure 6a & 6b). The zeta potential indicates the degree of repulsion between adjacent and similarly charged particles in dispersion. For the zinc nanoparticles synthesized from Cinnamomum zeylanicum bark extract, least particle size and high zeta potential values were recorded. The zeta potential value indicated good stability with high potential. Particle size is measured by the SZ-100 using dynamic light scattering (DLS).
Figure 6: 6(a) and 6(b) Showing Dynamic light scattering Cinnamomum zeylanicum results showing that particle size and zeta potential of Zn nanoparticles.

The direction of the particle motion determines if the charge is negative or positive, and the speed of the particles determines the magnitude of the charge (zeta potential). The reported zeta potential result can then be used as an indicator of the dispersion stability.
The zinc nanoparticles used in this study were having the mean diameter of 20nm as shown by TEM micrographs. Figure 7 shows the image of nanoscale zinc particles and appears slightly aggregated due to the absence of surface protecting ligands and it is spherical in shape. The particles were crystalline in nature as revealed by the high magnification TEM image of nanoparticles and the lattice of zinc was clearly seen. Antimicrobial efficacy of Cinnamomum zeylanicum stem bark-extract mediated Zn Nanoparticles CZnNPs have very strong inhibitory action against fungal sp, Gram-positive and Gram- negative bacteria (Plates 1 & 2). Three concentrations of CZnNPs (170, 100, 50ppm) were prepared and were applied against an array of fungal species viz., Meyerozyma caribbica Aspergillus parvisclerotigenus, Meyerozyma guilliermondii, Rhizopus oryzae, uncultured fungus clone, Aspergillus oryzae, Trichoderma asperellum and bacterial species viz., Sphingobacterium thalpophilum, Uncultured organism clone, Ochrobactrum sp, Uncultured Achromobacter sp, Uncultured bacterium clone, Sphingobacterium sp, Acinetobacter sp, Uncultured soil bacterium, Ochrobactrum sp. Which were isolated from drinking water PVC pipe. The higher concentration (170ppm) of ZNPs showed significant antimicrobial effect (Tables 1 & 2) compared with other concentrations (100, 50ppm). Nanoparticles have larger surface area available for interactions, which enhances bactericidal effect than the large sized particles; hence, they impart cytotoxicity to the microorganisms [25]. The mechanism by which the nanoparticles are able to penetrate the bacteria is not understood completely, but studies suggest that when bacteria were treated with zinc nanoparticles, changes took place in its membrane morphology that produced a significant increase in its permeability affecting proper transport through the plasma membrane [26,27], leaving the bacterial cells incapable of properly regulating transport through the plasma membrane, resulting into cell death [28]. During the present study, different concentrations of Zinc nanoparticles were tested to find out the best concentration that can have the most effective antibacterial property than fungi. Zinc nanoparticles synthesized from the Cinnamomum zeylanicum bark extract proved to be more potent. The antimicrobial activity is probably derived, through the electrostatic attraction between negative charged cell membrane of microorganism and positive charged nanoparticles [29]. The mechanism involved here is the penetration of zinc nanoparticles into the cell walls and modulate the cellular signaling by dephosphorylating putative key peptide substrates on tyrosine residues. It reflects that Zinc nanoparticles have an excellent anti-bacterial and anti-fungal effect and potential in reducing bacterial, fungal growth for practical applications [30].
Plate 1: symnthesized Zn nanoparticles of cinnamomumzeylanicumbark extract showing effective antibacterial activity towards gram positive and gram negative bacteria

Plate 2: symnthesized Zn nanoparticles (DF<0.05)of cinnamomumzeylanicumbark extract showing effective antifungal.
Figure 7:TEM image of Cinnamomum zeylanicum bark extract mediated synthesis of Zn nanoparticles showing spherical shaped particles.

Table 1::In vitro antibacterial studies of bacteria present in drinking water PVC pipelines using Cinnamomum zeylanicum bark extract of Zinc nanoparticles as inhibitors

Table 2:In vitro antifungal studies of fungi present in drinking water PVC pipelines using Cinnamomum zeylanicum bark extract of Zinc nanoparticles as inhibitors.

Synthesis of zinc nanoparticles from Cinnamomum zeylanicum bark extract shown structural characterizations demonstrate that the synthesized products are spherical and crystalline in structure and their diameter was about 20nm. The antibacterial activity performance of Zn nanoparticles was done by using disc diffusion method. The zone of inhibition increases with the increase in Zinc nano particle concentration and decrease in particle size. However, future studies on the biocide influence of this nano material on other Gram- positive and Gram-negative bacteria are necessary in order to fully evaluate its possible use as a new bactericidal material. Green synthesis of zinc nanoparticles promises the up scalable and non-toxic method of production of a variety of metallic nanoparticles. Zinc nanoparticles were synthesized from Cinnamomum zeylanicum bark extract showed good antimicrobial activity against bacteria and fungi. Applications of Zn nanoparticles based on these findings may lead to valuable discoveries in various fields such as medical devices and antimicrobial systems. Maximum zone of inhibition was identified at 170ppm when compared to 100ppm and 50ppm, these Zn nanoparticles shown best results towards bacteria and minimum inhibition towards fungi.
© 2017 Supraja N, et al. This is an open access article distributed under the terms of the Creative Commons Attribution License , which permits unrestricted use, distribution, and build upon your work non-commercially.
a Creative Commons Attribution 4.0 International License. Based on a work at www.crimsonpublishers.com.
Best viewed in